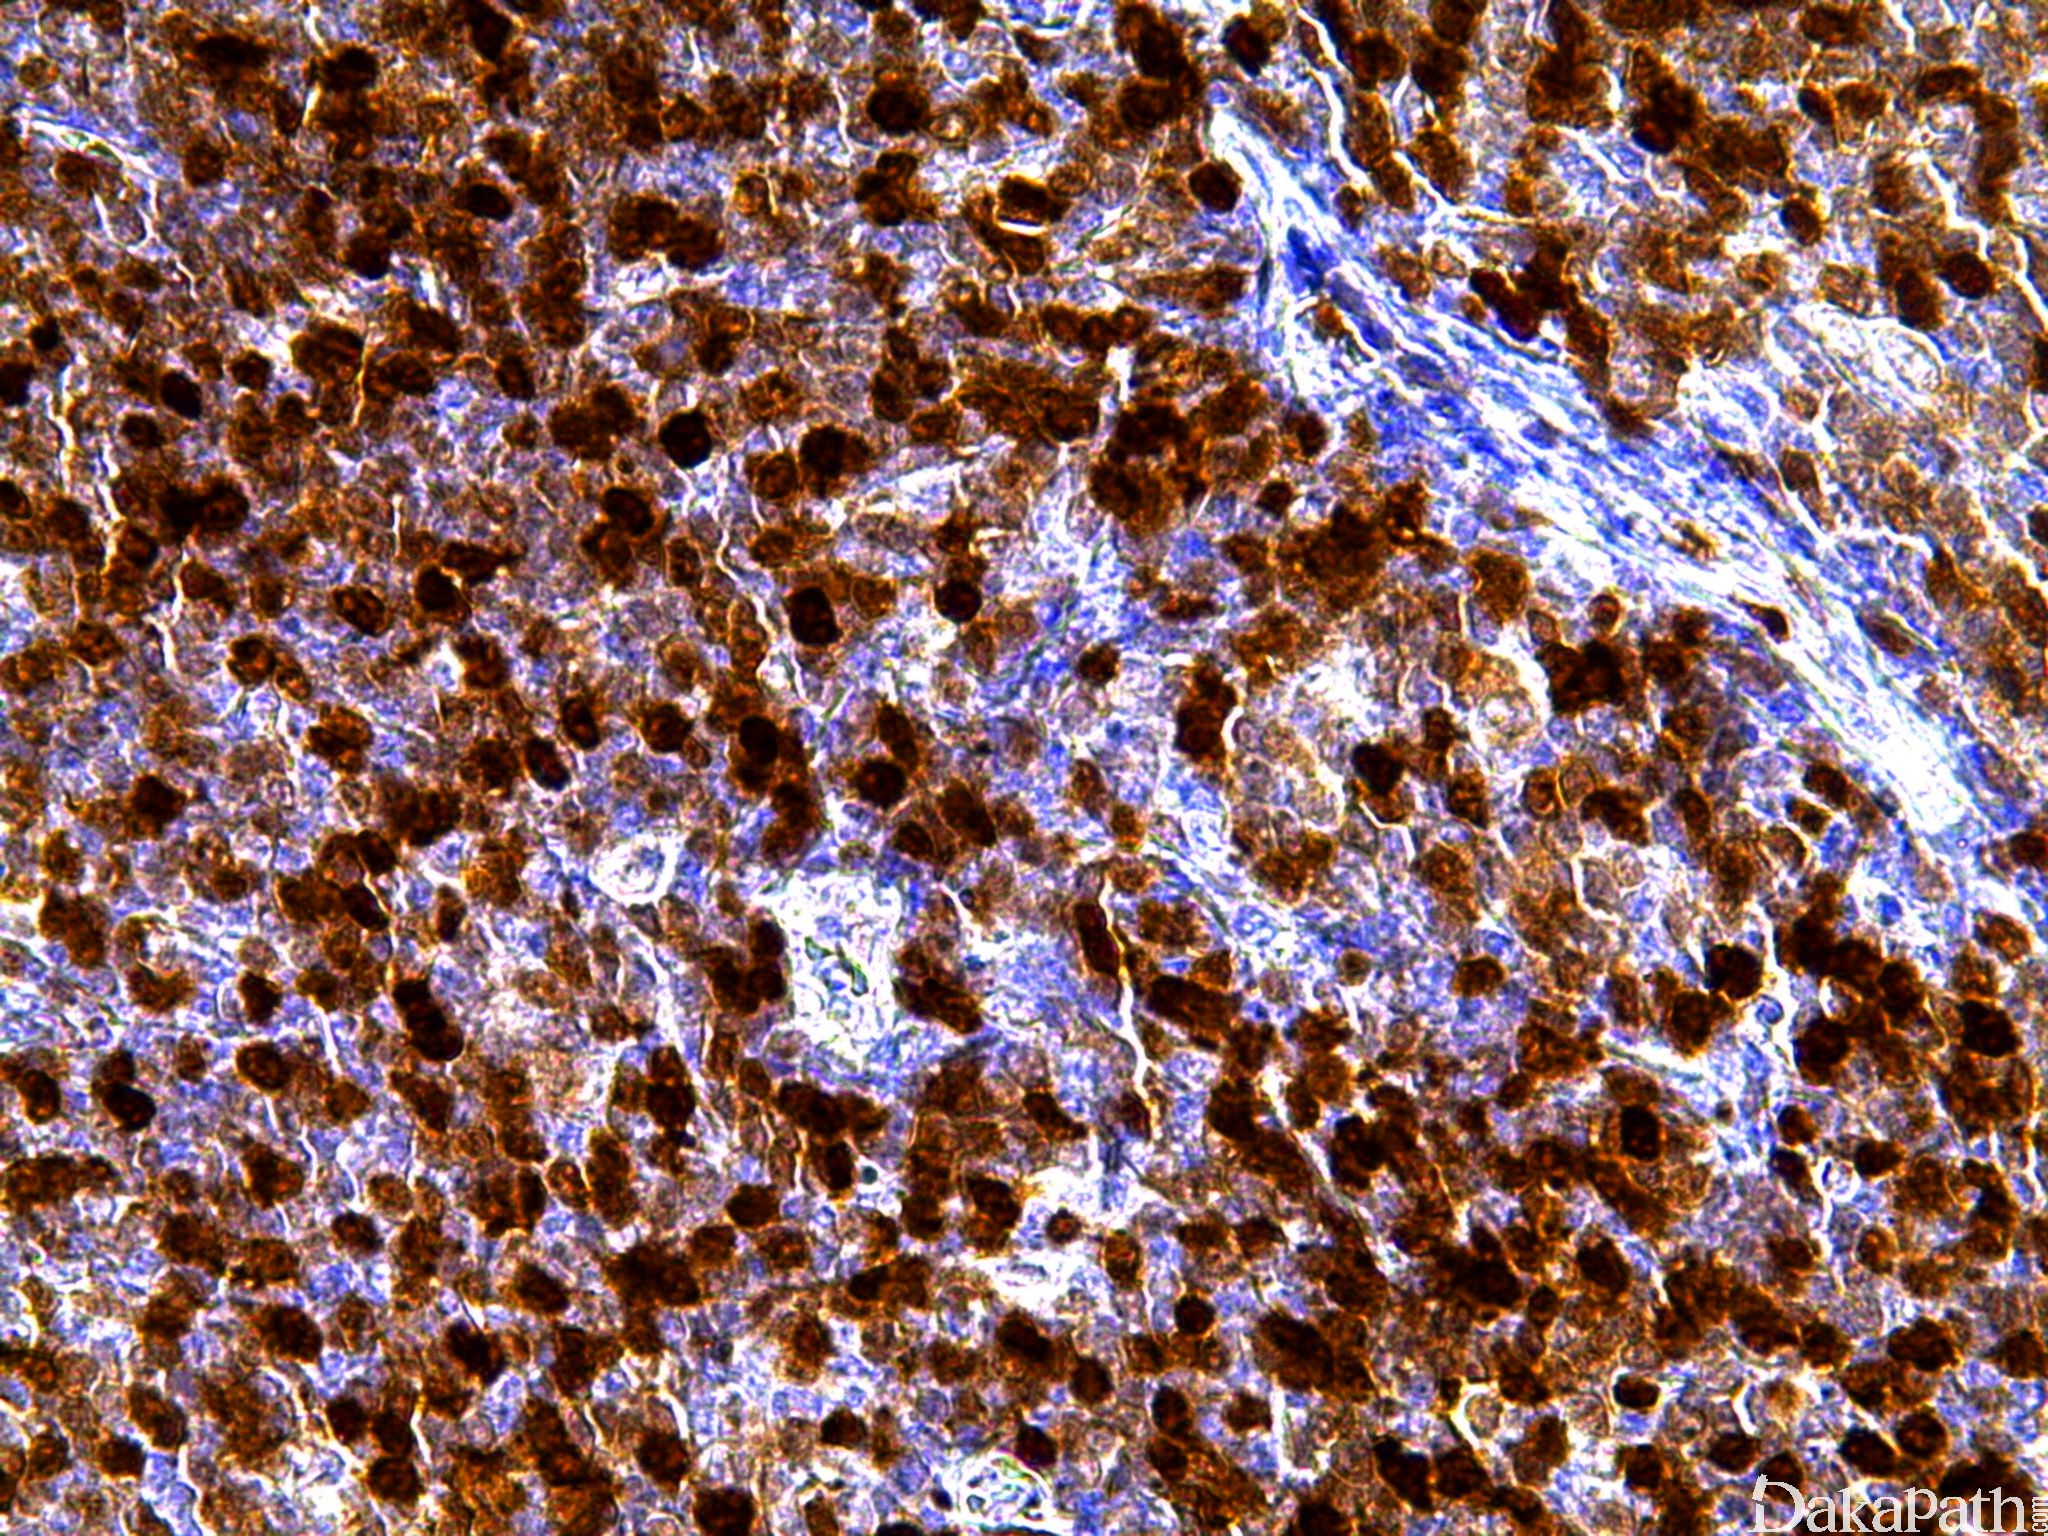

TCL1
别名: T cell leukemia/lymphoma protein、TCL1A、p14TCL1
概述:
T 细胞白血病/淋巴瘤蛋白,见于胚胎发育期淋巴细胞的细胞核和胞浆,染色体异位可引起 T 细胞白血病和 B 细胞淋巴瘤。
信号定位: 胞质、胞核
在病理学中的应用:
成熟 B 细胞淋巴瘤的诊断及分型
商品化试剂(排名不分先后,本网站对抗体质量不负责!)
公司 | 克隆号 | 即用型(ml) | 原液(ml) | ||||
基因科技 | EP105 | / | 2 | 4 | 7 | / | 0.2 |
在肿瘤中的表达情况:
几乎全部阳性(≥95%的病例阳性): 弥漫大 B 细胞淋巴瘤,c-myc 重排、母细胞性浆细胞样树突状细胞肿瘤、恶性横纹肌样瘤、非典型畸胎瘤样横纹肌样瘤、卵巢无性细胞瘤、睾丸原位生殖细胞瘤
通常阳性(<95%,≥75%的病例阳性): Burkitt 淋巴瘤、睾丸精原细胞瘤
经常阳性(<75%,≥55%的病例阳性): 卵巢卵黄囊瘤
有时阳性(<55%,≥35%的病例阳性): 弥漫大 B 型大 B 细胞淋巴瘤,非特指型
少数阳性(<35%,≥15%的病例阳性): 弥漫大 B 细胞淋巴瘤,生发中心细胞来源、纵膈精原细胞瘤、弥漫大 B 细胞淋巴瘤,非生发中心来源
偶尔阳性(<15%,≥5%的病例阳性): 纵膈大 B 细胞淋巴瘤
几乎全部阴性(<5%的病例阳性): 子宫内膜绒毛膜癌、胚胎性癌